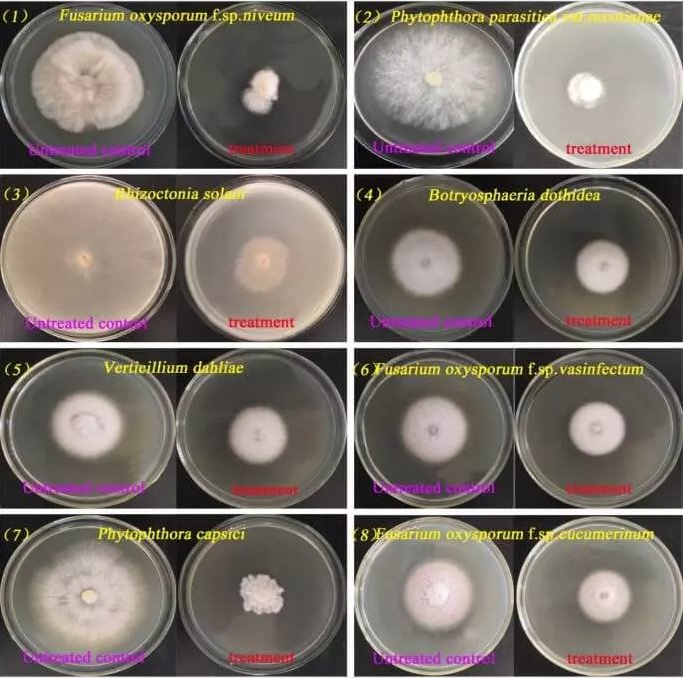
Producing Nematode Control Prevention of Soil Borne Diseases Improving Quality Streptomyces Microflavus

Overview & Basic Information
Model NO.
Streptomyces Microflavus
Application
Vegetables, Flowers, Fruit
Infection On Soil
Physiological Neutral
Chemical Character
Chemical Neutral
Type
Bacterial Fertilizers
Product Description
Introduction: Streptomyces microflavus is a soil bacterium with numerous benefits, making it valuable in sustainable agriculture. It fixes atmospheric nitrogen, produces antibiotics, breaks down organic matter, and improves soil structure. This natural antifungal can suppress soil-borne pathogens, leading to better soil quality and increased crop yields.
Composition & Specifications
- Bacteria count: 3* 10^9 CFU/g
- Formulation: Wettable Powder
- Packaging: 1 kg or 25 kg per bag
- Shelf Life: 24 months (Store in dry, cold conditions)
Target Pathogens
This product is effective against a wide range of diseases including Fusarium wilt, Rhizoctonia root rot, Phytophthora blight, and Verticillium wilt. It specifically targets pathogens such as Fusarium oxysporum, Phytophthora parasitica, and Rhizoctonia Solani.
Mode of Action
- Antagonistic Activity: Produces bioactive compounds (antibiotics, enzymes) that inhibit growth of harmful fungi and bacteria.
- Direct Disruption: Targets specific cellular processes like cell wall synthesis and DNA replication of pathogens.
- Systemic Resistance: Triggers plant defense mechanisms, enhancing the natural immunity system to fight infections.
Key Benefits
- Broad-spectrum control available for organic farming.
- Environmentally friendly and organic antifungal for plants.
- Safe for use in various agricultural settings without drug resistance.
- Enhances plant health by aiding nutrient uptake.
- Persistent defense mechanism against future infestations.
Application Rate
- Foliage spray: 2-3 grams per liter of water.
- Soil application: 2-3kg per hectare applied around the base of plants.
- Pre-transplanting: 2 kg mixed with 20 kg of farm yard manure per acre.
Soil Enhancement & Bio-fertilizer Production
How it helps the soil: It supports nitrogen fixation, suppresses soil-borne diseases via antibiotic production, assists in organic matter decomposition, and improves soil aggregation for better water-holding capacity.
Solid-state Fermentation Process:
- Select substrates like rice straw, wheat bran, or corn cob.
- Inoculate substrate with S. microflavus evenly.
- Incubate under controlled temperature, humidity, and aeration.
- Harvest and dry the resulting bio-organic fertilizer.
Frequently Asked Questions
1. Can I get a free sample for testing?
Yes, 20-50 gram free samples can be provided with freight collect.
2. What is the Minimum Order Quantity (MOQ)?
For sample testing, the MOQ is 1 kg. For commercial orders, the total MOQ is 100 kgs.
3. Do you provide documents for local registration?
Yes, we provide the necessary documentation to support distributors with their local registration process.
4. Can you provide neutral packing or re-labeling services?
Yes, both neutral packing and re-labeling services are available upon request.
5. What are the accepted payment terms?
We accept T/T Bank wire, LC at sight, Paypal, Payoneer, and Alipay.
6. What is the standard delivery time?
Usually, delivery takes about 10-20 days, depending on the specific products and order quantity.





 Gray Medical
Gray Medical